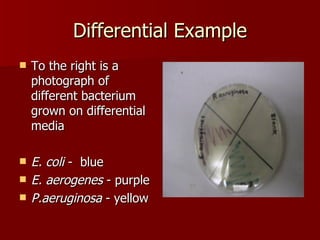
Differential Example To the right is a photograph of different bacterium grown on differential media E. coli  -  blue E. aerogenes  - purple P.aeruginosa  - yellow

Microorganisms require nutrients like carbon, nitrogen, hydrogen, oxygen, sulphur and phosphorus to grow. They can be classified based on how they obtain carbon and energy, such as heterotrophs, autotrophs, chemotrophs and phototrophs. Selective and differential media can encourage or inhibit growth of specific microorganisms and compare different types. Limiting temperature, pH, gas levels and osmotic pressure can inhibit microbial growth physically, while antimicrobial agents and antibiotics can inhibit growth chemically by damaging cell structures. Overuse of antibiotics increases the risk of antibiotic resistant pathogens developing.